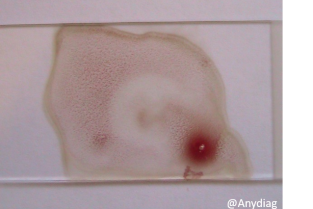
eff9e40b51127c2584b10473ff5d69d0

Présentation de la formation
Le Groupe d’Étude en Biologie Médicale vous donne rendez-vous pour ses 2èmes Journées de la Biologie Médicale, les 20 et 21 mars 2026, au Domaine du Gouverneur**, à seulement 30 minutes de Lyon.
Après le succès de la première édition en 2025 au Pouliguen, le GEBM pose cette fois ses valises en région Rhône-Alpes, dans un cadre d’exception au cœur d’une nature préservée.
Au programme : deux jours d’un programme scientifique riche, animés par des experts en biologie médicale et en médecine interne. Infectiologie, oncologie, uro-néphrologie, hématologie, médecine préventive… autant de thématiques abordées avec comme objectifs : mettre à jour vos connaissances, répondre à toutes vos questions et vous faire progresser quel que soit votre niveau.
L’originalité de ces journées : deux après-midis entiers d’ateliers en petits groupes, avec microscopes de dernière génération et cas pratiques pour rendre la biologie médicale encore plus concrète et utile en clientèle.
Travail et partage, convivialité et détente seront au cœur de ce rendez-vous unique.
Attention, les places sont limitées : inscrivez-vous vite !"
Moyens pédagogiques : ordinateur, vidéo projecteur et le support pédagogique envoyé avant la formation par mail.
Cette formation est en présentiel.
Prérequis
Etre vétérinaire ou étudiant vétérinaire (niveau assistant ou résident).
Inscription avant le
06 mars 2026
Objectifs pédagogiques
- Détecter précocemment des maladies et realiser le suivi biologique grâce à un bilan biologique adapté au patient.
- Connaitre, reconnaitre, interpréter les principales anomalies hématologiques ; comprendre l’intérêt des tests réalisables au chevet du patient.
- Réaliser et exploiter les examens cytologiques des lésions les plus fréquentes.
- Connaitre et intégrer dans une démarche diagnostique les examens courants et spécialisés lors de suspicion de lymphome.
- Utiliser les outils diagnostiques en infectiologie.
- Evaluer les désordres lipidiques.
- Reconnaitre et prendre en charge les maladies rénales.
- Réaliser et interpréter les analyses urinaires.
Informations pratiques
Vous retrouverez toutes les informations pratiques concernant l'accessibilité, l'hébergement, la restauration, etc ..., dans une plaquette à part.
Le nombre minimum de participants est de 17.
Le nombre maximum de participants est de 40.
Formateurs
Jéremy Beguin (DV, Dipl. ECVIM-CA (Oncology), CEAV Médecine Interne, Ms, PhD), Corine Boucraut-Baralon (DV, Ancien Maître de Conférences), Pierre Deshuillers (DV, Dip. ACVP (Clinical Pathology), Enseignant ENVA), Maxime Kurtz (DV, Dip. ECVIM), Christelle Maurey-Guenec (DV, PhD, Dip. ECVIM-CA), Laetitia Piane (DV, Dip. ECVCP), Benoit Rannou (DV, Dip. ACVP), Delphine Rivière (DV, CES de Biochimie et Hématologie Clinique Animales), Nicolas Soetart (DV, ancien résident pathologie clinique, CES Hématologie et biochimie vétérinaire, DU Mycologie médicale), Catherine Trumel (DV, Dip. ECVCP, PhD)
Modalités d'apprentissage
17h15 de programme se déclinant en 5h15 de cours, 6h de TD, 6h de TP
Cette formation comporte un support pédagogique.
Validation
Base de points pour cette formation : entre 0.99 et 1.29 CFC.
Une évaluation des connaissances est réalisée. Cette évaluation permet au vétérinaire participant en cas de réussite (note supérieure à 10) de doubler les points de formation continue obtenus.
Conditions d’accessibilité des personnes en situation de handicap
Si vous êtes en situation de handicap, merci de nous le faire savoir afin de mettre en place les mesures nécessaires. Notre référente handicap, chargée de l’intégration de la sécurisation de votre parcours est disponible : referenthandi@afvac.com.
Pour les formations d’une journée et plus, en cas de restrictions alimentaires, veuillez nous contacter au moins 10 jours avant la formation.
Renseignements scientifiques
Rannou Benoît
b.rannou@azurvet-lab.fr
Programme de formation
20 mars 2026
Benoit Rannou
Maxime Kurtz
Maxime Kurtz
Catherine Trumel
Delphine Rivière
Delphine Rivière
Catherine Trumel
21 mars 2026
Maxime Kurtz
Maxime Kurtz
Catherine Trumel
Delphine Rivière
Catherine Trumel
Delphine Rivière
Inscriptions et tarifs
Les tarifs proposés sont ceux calculés en fonction de la date et de votre statut
Pour procéder à un achat ou à l'inscription à une formation, veuillez vous connecter ou créer votre compte.
Formation seule
Frais d'inscription 2 jours Vétérinaire Adhérent AFVAC
Tarif HT416,67 €Tarif TTC500,00 €Frais d'inscription 2 jours Vétérinaire non-adhérent AFVAC
Tarif HT675,00 €Tarif TTC810,00 €Frais d'inscription 2 jours Vétérinaire Adhérent AFVAC
Tarif HT270,83 €Tarif TTC325,00 €Frais d'inscription 2 jours Vétérinaire non-adhérent AFVAC
Tarif HT437,50 €Tarif TTC525,00 €
